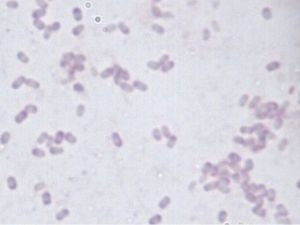
納豆芽孢桿菌

形態特徵
納豆芽孢桿菌通常為(0.7-0.8)um×(2.0-3.0)um,革蘭氏陽性。生長在葡萄糖瓊脂的細胞原生質染色均勻。芽孢橢圓形或柱狀,中生或偏中生,即使孢囊膨大,也不顯著,有鞭毛,能運動。生長溫度最高位45-55℃,最低為5-20℃。孢子耐熱性強。
生態習性
納豆芽孢桿菌
納豆芽孢桿菌納豆芽孢桿菌是從納豆製品中或從自然界的稻、谷上面分離得到。日本傳統的做法是把煮熟的大豆趁熱裝在用稻草做成的器皿里,利用稻草上附著的納豆菌自然發酵而做成的。用這種方法做成的納豆中,除了納豆菌以外,還含有其他雜菌,不僅衛生不過關,而且質量也不好。孢子型納豆菌是具有耐酸、耐熱特性的有益菌,在胃酸下四小時存活率為100%,同時具有強力的病原菌抑制能力,是各種益菌當中,對環境耐受力最好可以直達小腸的菌種之一,口服後可改變人體腸道菌叢生態,幫助消化道機能正常化,以使排便順暢,維持體內生理環保。可以產酸,調節腸道菌群,增強動物細胞免疫放應。並能生成多種蛋白酶(特別是鹼性蛋白酶)、糖化酶、脂肪酶、澱粉酶,降解植物性飼料種某些複雜的碳水化合物,從而提高飼料的轉化率。
經濟價值
利用納豆菌可以製造納豆。因納豆菌是嗜氧菌,接觸空氣是很重要的。納豆菌在通過吞噬大豆蛋白來繁殖的時候,產生出的無數酵素納豆激酶和維生素K,具有神奇的藥效,可以治療三高(高血糖,高血壓,高血脂)和溶解血栓的作用,而且還能產生出胺基酸的美味。納豆常配入海鮮醬油、芥末等調味料直接食用,也可烹製各類菜餚。納豆需要冷藏保鮮,保質期一般在7~10天。近幾十年來,隨著納豆的有益健康的功能不斷被發現,納豆在日本風靡全國,不斷掀起“納豆熱潮”。
製造納豆
納豆的家庭製作、保存和食用
一、使用器皿和材料:①大豆500g。②廣州農牧開發有限公司納豆菌5g。③高壓鍋。④不鏽鋼盆。⑤泡沫飯盒等淺容器。⑥泡沫箱子。⑦2立升長方形塑膠瓶子或暖水袋。⑧溫度計
二、泡豆蒸豆:將大豆充分洗淨後,加入3倍量的水浸泡一夜後,倒掉水放進高壓鍋內蒸到大豆用手捏碎的程度,大約45分鐘。如沒有高壓鍋,煮水時一次不要放得太多。為了保持大豆的原汁原味,最好是蒸。
三、接種納豆菌:將納豆菌用50ml熱水(溫度最好38-45℃,溫度太高會殺死納豆菌)溶解後,均勻地加入到熱大豆中(溫度最好38-45℃,溫度太高會殺死納豆菌),迅速攪拌均勻,分裝在7個泡沫飯盒裡,厚度大約2cm,上面苫上紗布或者在飯盒與飯盒蓋之間架上一雙筷子,使其充分接觸空氣。因納豆菌是嗜氧菌,接觸空氣是很重要的。但發酵好以後,要蓋好蓋,用膠帶封住口,避免接觸空氣利於長期保存。
四、在恆溫下發酵14-36小時:在乾淨的大泡沫箱內放入幾瓶裝滿50℃熱水的長方形塑膠瓶子,把已接種上納豆菌的泡沫飯盒擺在瓶子上,箱內理想溫度是42℃。如箱內溫度降到38℃時,瓶內重新換入50℃的熱水。如此反覆更換瓶內熱水,發酵14-36小時,大豆表面產生了白膜,有粘絲出現後,大豆就變成了納豆。如沒有泡沫箱子,也可使用大紙盒,四周包上棉被和電褥子,或者箱內插入一隻45℃的電燈泡等方法來保持箱內恆溫。注意多接觸空氣。
五、後熟(活菌低溫休眠):在38-42℃的恆溫下發酵14-36小時,然後放在冰櫃內低溫熟成數小時後,做好的納豆無論是外觀還是口感都會更好。因此建議納豆做好後,先放入冰櫃內低溫熟成數小時以後再食用或長期保存。
六、製作關鍵:①注意保持38-42℃的恆溫。②納豆菌要接種到熱熱的大豆中(溫度最好38-45℃,溫度太高會殺死納豆菌)。
七、納豆菌的保存:廣州農牧開發有限公司納豆菌菌種因處於孢子狀態特別穩定,只要放在陰涼乾燥處就能長期保存。但開封后一定要放在冰櫃內低溫保存。
八、注意事項:心血管疾病患者在服用血液凝固阻止劑新香豆素時,納豆中維生素K2能使新香豆素失去藥效,所以不要食用納豆。
九、科學的食用方法:納豆雖然有很高的藥用價值,但因它特有的臭味及粘絲,使一部分人對它敬而遠之。那么怎樣吃,臭味消失粘絲減少呢?對於討厭納豆臭味的人,可以用一些香味大的食品如:圓蔥、大蔥、蝦皮、小魚等來中和納豆的臭味,同時還能提高抗酸化能力。討厭納豆粘絲的人,可以把納豆加水稀釋1-2倍後,再加入醬油等調料一起吃。還可以把納豆切碎後,加入到涼湯中一起喝。納豆的最佳科學組合:1、納豆+圓蔥2、納豆+大白蘿蔔末3、納豆+朝鮮辣白菜4、納豆+生蛋黃5、納豆+海帶6、納豆+芝麻+蜂蜜。
十、怎樣提高納豆的保健效果:
1、晚餐吃納豆效果最好。通過實驗,專家認為:食用納豆1小時至12小時之間納豆激酶發揮溶解血栓的功能。而據統計腦梗塞、心肌梗塞等各種血栓病,發病時間多為清晨及星期一。因此每晚或星期日晚餐吃效果最好。
2、儘可能不加熱吃。納豆激酶不耐熱,加熱到70℃活性就消失了。所以生吃效果最好。
3、必須堅持每天吃。納豆激酶進入體內後,其活性維持12小時。所以儘可能每天吃30-100g最理想。
4、保質期稍過也能吃。納豆的保質期為一周,它在冰櫃內低溫保存過程中,還在進行著緩慢的低溫熟成發酵,納豆激酶和維生素K2也在不斷增加。但保質期過後雖然也能吃,只是納豆菌為了生存不斷分解蛋白質,其結果臭味逐漸增加。
十一、工廠規模化生產納豆:如果工廠化生產納豆,根據產量選擇合適的自動化清洗、浸泡、蒸煮、恆溫發酵、低溫乾燥設備。

